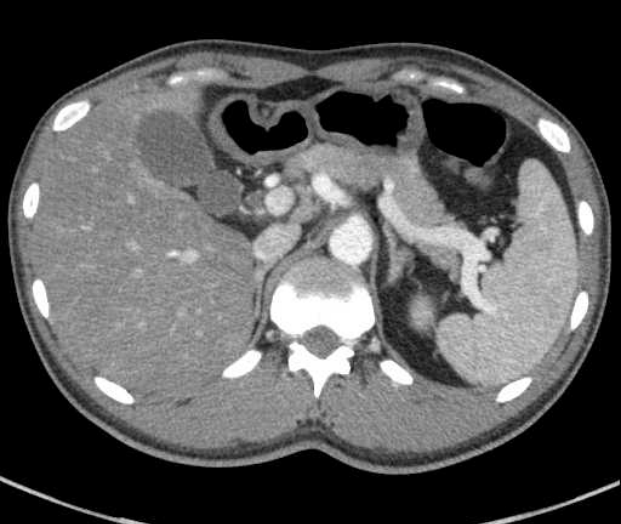
kjm-91-2-233f1.tif

급성 담낭염으로 합병된 지역사회획득 메티실린 내성 황색포도알균 세균혈증 1예
- 박정화, 김윤정, 신승환, 이상아, 김민정, 장현하, 김신우
Community-acquired Methicillin-resistant Staphylococcus aureus Bacteremia Complicated by Acute Cholecystitis
- Jung Hwa Park, Yoon Jung Kim, Seung Hwan Shin, Sang Ah Lee, Min Jung Kim, Hyun-Ha Chang, Shin-Woo Kim
- Received April 4, 2016; Revised May 4, 2016; Accepted July 6, 2016;
- Abstract
-
황색포도알균은 피부나 점막, 콧구멍에서 집락균으로 존재하며, 피부 및 점막의 방어가 파괴될 시 주변조직 및 혈류로 침투하여 감염이 발생한다. 황색포도알균 세균혈증은 감염심내막염, 감염척추염 등의 다양한 감염성 합병증을 일으키나 간담도염은 흔치 않은 것으로 알려져 있다. 국외의 경우 면역저하자 등에서 MRSA 담낭염이 드물게 보고되었으나 국내에는 이에 대한 보고가 없다. 본 증례에서는 MRSA 감염의 위험 인자가 없는 건강한 성인에서 급성 담낭염으로 합병된 CA-MRSA 세균혈증을 경험하여 문헌고찰과 함께 보고하는 바이다.
- Abstract
-
Community-acquired methicillin-resistant Staphylococcus aureus (CA-MRSA) bacteremia is an uncommon infection in Korea. Typically, staphylococcal bacteremia is associated with various metastatic infections, such as multiple liver and spleen abscesses, infectious spondylitis, or infective endocarditis. Solitary cholecystitis as the only manifestation of CA-MRSA bacteremia has not been reported. Therefore, we report a case of CA-MRSA bacteremia complicated by acute cholecystitis.
- 서 론
- 서 론
황색포도알균은 주로 콧구멍, 겨드랑이, 인두 및 손상된 피부에서 서식하는 것으로 알려져 있으며[1], 피부 혹은 점막의 방어가 파괴되어 주변 조직 및 혈류로 균이 침투할 때 감염이 발생하게 된다[2]. 황색포도알균 세균혈증은 감염심내막염, 감염척추염, 다발농양 등의 다양한 감염성 합병증을 일으키나 간담도염은 흔치 않은 것으로 알려져 있다[2]. 국외의 경우 면역저하자 혹은 감염의 위험 인자가 있는 환자들 가운데 methicillin-resistant Staphylococcus aureus (MRSA) 담낭염이 드물게 보고되었으나[3-5], 국내에는 이에 대한 보고가 없었다. 이에 저자들은 급성 담낭염으로 합병된 community-acquired methicillin-resistant Staphylococcus aureus (CA-MRSA) 세균혈증 1예를 문헌고찰과 함께 보고하는 바이다.
- 증 례
- 증 례
환 자: 38세 남자주 소: 2주간의 열감, 전신 쇠약현병력: 2주 전 열감 및 오한, 전신 쇠약 등이 발생하였고, 1일 전 고열 및 전신 쇠약 악화로 타 병원 응급실에서 혈액 검사 및 복부 컴퓨터단층촬영술 시행 후 하루간 경과 관찰을 하였으며(Fig. 1), 뚜렷한 원인을 확인하지 못해 본원 응급실로 전원되었다.과거력: 이전 특이 병력은 없었으며, 속쓰림으로 입원 1개월 전 식도위내시경 검사 후 역류식도염을 진단받고 투약 중이었다.개인력 및 가족력: 비흡연, 비음주가였으며 가족력상 특이사항은 없었다.이학적 소견: 입원 당시 체온 39.2℃, 혈압 140/99 mmHg, 심박수 130회/분, 호흡수 20회/분이었다. 의식은 명료하였으나 급성 병색을 보였고, 황달이 확인되었다. 복부 신체 검사상 압통은 없었고, 피부 감염 병소 또한 없었다.검사실 소견: 혈액 검사에서 백혈구 3,110/mm3, 혈색소 7.0 g/dL, 혈소판 122,000/mm3, 아스파테이트아미노전달효소 310 U/L, 알라닌아미노전달효소 256 U/L, 알칼리인산분해효소 134 U/L, 총 빌리루빈(total bilirubin, TB) 10.22 mg/dL, 직접 빌리루빈(direct bilirubin, DB) 5.11 mg/dL 그리고 C-반응단백(C-reactive protein, CRP) 0.67 mg/dL, 적혈구 침강속도 2 mm/hr였다. 혈액 응고 검사 및 소변 검사의 이상 소견은 없었다.치료 및 경과: 입원 직후 혈액 배양 3쌍을 시행하였고, 경험적 항생제인 cefotaxime을 처방하였으나 하루 2-3회 발열이 지속되었다. 환자는 전신 쇠약, 식욕부진 이외에 뚜렷한 증상이 없었다. 황달 및 빈혈 동반으로 용혈성 질환 의심하 골수생검을 하였으나 거대 적혈모구 빈혈이 진단되어 약물을 복용하였다. 이후 혈액 배양에서 혈액 3쌍 모두 MRSA가 배양되었으며, 항균제 감수성 검사는 VITEK system으로 시행하여 ciprofloxacin, clindamycin, erythromycin, gentamicin, rifampin, teicoplanin, vancomycin에 감수성을 확인한 후 meropenem 및 vancomycin으로 항생제를 교체하였다. 원발 병소의 확인을 위해 시행한 흉부 및 복부 컴퓨터단층촬영술에서 간담도의 특이 소견은 확인되지 않았으나, 폐색전증이 새롭게 발견되어 enoxaparin을 투약하였다(Fig. 2). 감염심내막염을 고려하여 시행한 경흉부 심장 초음파에서 이상 소견은 없었다. TB 12.52 mg/dL, DB 9.86 mg/dL로 상승 추세를 보였으나, 항생제 교체 이후 TB 5.05 mg/dL, DB 4.35 mg/dL까지 저하를 보이며 복부 증상은 여전히 호소하지 않았다. 항생제 교체 5일째 혈액 배양에서 균 음전이 확인되며 발열은 없었으나, CRP 9.3 mg/dL로 상승 지속되어 양전자방출단층촬영술을 시행하였다. 담낭의 18F-fluorodeoxyglucose 섭취 증가가 확인되었고(Fig. 3), 이외의 이상 소견은 없어 담낭염 의심하 응급 경피 간경유담낭배액술을 시행하였다. 담즙 배양 결과 혈액 배양 시와 동일한 항균제 감수성을 가진 MRSA가 동정되었으며(Table 1), 배액 이후 간기능 검사 및 혈청 CRP 수치는 감소하였고, 전신 쇠약도 호전되었다. 약 3주간 정맥내 주사 항생제 지속 후 경구 항생제로 변경하여 퇴원하였으며, 폐색전증으로 약 4주 후 복강경하 담낭 절제술을 시행하였다. 술 후 조직검사 결과 만성 염증 소견이 확인되었으나 악성 소견은 없었다.
- 고 찰
- 고 찰
황색포도알균은 건강한 성인에서 피부나 점막, 콧구멍에서 집락균으로 존재한다[1]. 포도상알균 감염은 주로 피부 및 연조직염, 감염척추염, 다발농양 등과 연관되어 있으며, 일반적으로 피부나 점막의 손상으로 인해 주변 조직 및 혈행으로 전파되나[2], 위장관 내에서 황색포도알균은 정상 균무리로 존재하지 않으므로 이에 의한 담낭염은 드문 것으로 알려져 있다[6]. MRSA 감염은 주로 병원 및 의료시설과 연관이 있으며, 고령, 최근 입원 병력, 혈관내 장치, 투석, 면역저하, 최근의 항균제 치료 등의 위험 인자가 있는 경우에 발생하는데[7], community-acquired methicillin sensitive Staphylococcus aureus (CA-MSSA)와 비교하여 CA-MRSA에서 메티실린 내성획득의 위험 인자는 1년 이내 요양기관에 거주하였거나, 1년 이내 피부 및 연조직염을 앓았던 경우, 1년 이내 MRSA의 보균력이 있었던 경우, 1개월 이내 중증 질환자와 긴밀한 접촉을 가진 경우, 6개월 이내 cephalosporin에 노출된 경우를 들 수 있으나, 이 위험 인자들 중 어느 것도 CA-MSSA와 CA-MRSA를 명확히 구별할 수 있는 요소는 확인되지 않았다[8]. 또한 CA-MRSA는 HA-MRSA와 비교하여 비베타락탐계 항생제인 erythromycin, clindamycin, ciprofloxacin, rifampin, tetracycline 등에서 더욱 감수성을 지니는 특징이 있으며, 본 환자의 혈액 및 담낭 배양 검사에서 위의 특징을 만족하는 MRSA 균주가 동정되었다[8]. 국외의 경우 MRSA에 의한 담낭염이 현재까지 약 10여 예만이 보고되었고, Martin 등[4]은 만성 신부전증으로 혈액투석 중인 67세 여성에서, 반복되는 MRSA 세균혈증으로 인한 담낭염을 보고하였다. 위 환자는 6개월 전 폐렴으로 입원시 혈액에서 MRSA가 분리되어 치료하였다. Nepal 등[5]은 두부외상에 의한 노년전 치매 및 발작, 당뇨를 앓고 있는 50대 여성에서 MRSA 세균혈증 및 담낭염을 보고하였다. 감염 경로는 명확치 않으나, 발작 및 의식 소실시 발생한 외상으로 인해 감염되었을 가능성을 고려하였다. 또 다른 예는 Nguyen 등[9]에서 보고한 사례로, 우대퇴동맥우회술 후 무릎 아래 절단술을 시행한 75세 남성에서 발생한 MRSA 세균혈증 및 담낭농흉으로, 입원 3개월 전 혈액에서 MRSA가 분리되어 치료하였다. 위 환자들은 모두 기저 질환이 있거나, MRSA 획득의 위험 인자가 있었다.2012년 국내에서 보고된 자료에 의하면, 황색포도알균이 분리된 1,627명 중 CA-MRSA 102명(13.0%), hospital-acquired methicillin sensitive Staphylococcus aureus (HA-MRSA) 253명(32.2%)으로 확인되었고, CA-MRSA의 경우 피부 및 연조직감염이 34예로 가장 흔하였고, HA-MRSA의 경우 폐렴이 51명으로 가장 흔하게 확인되었다[8]. 이외 중추신경계 감염이나 요로감염 등도 양쪽 군에서 드물게 확인되었으나 담낭염의 예는 없었으며, 본 증례의 환자는 CA-MRSA 세균혈증에 합병된 담낭염으로 국내에 보고된 바가 없는 드문 예였다[8]. 위 환자의 경우 혈관 삽입장치 및 외상 등 명확한 혈관내 원인이 없었으므로, 십이지장으로부터의 상행 감염을 통한 담낭염 및 패혈증의 발생을 고려해볼 수 있었다. Merchant와 Falsey [10]가 보고한, 혈액 및 담즙에서 황색포도알균이 확인된 환자 중, 3개월 전 담석증으로 내시경괄약근절개술을 시행했던 64세 여성이 있었다. 이외 감염의 위험 인자가 없어, 전비공 내에 집락되어 있던 황색포도알균이 콧물 삼킴 등으로 인해 십이지장으로 전파 후 담도관을 통해 감염되었을 가능성이 제기되었다. 그러나 당시 전비공의 배양이 없어 상기 가능성은 추정으로 남았다. 본 증례의 환자도 MRSA 감염의 위험 인자가 없었으며, 한달 전 식도위내시경을 시행한 것 이외에 병원 접촉이 없어 위 가능성에 대해 고려해볼 수 있었으나, 마찬가지로 전비공의 상재균 여부에 대한 조사가 시행되지 않아 알 수 없었다. 또한 환자에서 분리된 MRSA에 대해 SCCmec typing이나 Panton-Valentine leukocidin 독소 생성 여부 등 분자유전학적 특성을 조사하지 못한 점이 제한점으로 남았다.본 증례는 CA-MRSA 세균혈증 중 상당히 드문 형태인 급성 담낭염으로 합병된 증례로서 본 증례와 같이 상당히 다양한 질환의 형태로 세균혈증이 발현될 수 있으므로 임상에서 CA-MRSA 세균혈증을 진단 및 치료하는데 관심과 주의를 기울여야 할 것으로 사료된다.
Figure 1.
Computed tomography at another hospital showed no hepatobiliary tract abnormalities or gall bladder wall edema.
Figure 2.
Computed tomography of the chest revealed pulmonary thromboembolism of the right pulmonary artery (arrow).

Figure 3.
Positron emission tomography (PET) computed tomography (CT) revealed diffuse fluorodeoxyglucose-uptake by the gallbladder wall and fossa. Otherwise, PET CT showed no evidence of an abnormal hypermetabolic lesion suggesting malignancy.

Table 1.
Antibiotic sensitivity of the methicillin-resistant Staphylococcus aureus cultured from bile
- References
- References
REFERENCES
1. Noble WC, Valkenburg HA, Wolters CH. Carriage of Staphylococcus aureus in random samples of a normal population. J Hyg (Lond) 1967;65:567–573.
[Article] [PubMed] [PMC]3. Kim J, Gregson DB, Church DL. A case of acute cholecystitis caused by methicillin-resistant Staphylococcus aureus in an immunocompromised patient. Can J Infect Dis Med Microbiol 2011;22:e7–e9.
[Article] [PubMed] [PMC]4. Martin J, Miller D, Ménard GE. Treatment considerations for recurrent MRSA bacteremia leading to cholecystitis. J Gen Intern Med 2011;26:669–672.
[Article]5. Nepal SK, Giri S, Panday K. Successful treatment of methicillin-resistant Staphylococcus aureus bacteraemia and cholecystitis. BMJ Case Rep 2012;2012.
[Article]6. Fridkin SK, Hageman JC, Morrison M, et al. Methicillin-resistant Staphylococcus aureus disease in three communities. N Engl J Med 2005;352:1436–1444.
[Article] [PubMed]7. Kim HB. Community-associated methicillin-resistant Staphylococcus aureus (CA-MRSA). Korean J Intern Med 2007;72:120–130.8. Kim ES, Kim HB, Kim G, et al. Clinical and epidemiological factors associated with methicillin resistance in community-onset invasive Staphylococcus aureus infections: prospective multicenter cross-sectional study in Korea. PLoS One 2014;9:e114127.
[Article]
